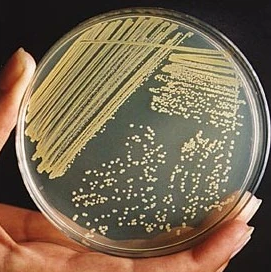

저는 대학교를 화학과를 나왔어요.
그래서 유기화학이나 기기분석 수업은 들었는데,
대학원은 약에 대해 공부하고 싶어서 생명과를 갔었습니다.
그래서 기본적인 분자생물학에 대해서도 잘 몰랐고, 어떤 실험 방법이 있는지는 전혀 몰랐어요.

그래서 오늘은 생명과 대학원에서 어떤 것을 배우는지
실험 위주로 한번 정리해볼게요.
생명과에 관심많은 분들이 보고 생각을 정리해보면 좋을 거 같아요.
1. SDS-PAGE (Sodium Dodecyl Sulfate Polyacrylamide Gel Electrophoresis):

- 단백질을 크기에 따라 분리하는 전기영동 기술입니다. SDS라는 계면활성제를 사용하여 단백질에 음전하를 부여하고, 폴리아크릴아마이드 겔을 통해 전기장을 걸어 단백질을 분리합니다. 주로 단백질의 분자량 측정, 순도 확인 등에 사용됩니다.
2.Western blot (웨스턴 블롯):

- SDS-PAGE로 분리된 단백질을 막으로 옮긴 후, 특정 단백질을 항체를 이용하여 검출하는 기술입니다. 특정 단백질의 존재 여부 및 양을 확인하는 데 사용됩니다.
3. PCR (Polymerase Chain Reaction, 중합효소 연쇄 반응):

-
- DNA의 특정 부위를 짧은 시간에 대량으로 증폭시키는 기술입니다. DNA 복제 효소와 프라이머를 사용하여 원하는 DNA 부위를 수백만 배로 증폭시킬 수 있습니다. 유전자 검사, 질병 진단, DNA 분석 등에 널리 사용됩니다.
4. 세포 배양 (Cell culture):
- 생물체에서 분리한 세포를 실험실 환경에서 인공적으로 키우는 기술입니다. 다양한 종류의 세포를 배양하여 세포의 특성, 기능, 반응 등을 연구하는 데 사용됩니다.
5. HPLC (High-Performance Liquid Chromatography, 고성능 액체 크로마토그래피):

- 액체 상태의 혼합물을 분리하는 기술입니다. 고압으로 용매를 컬럼에 통과시켜 혼합물의 각 성분을 분리하고 분석합니다. 주로 의약품, 식품, 환경 등 다양한 분야에서 물질 분석에 사용됩니다.
6. 원심분리 (Centrifugation):

- 원심력을 이용하여 혼합물을 밀도에 따라 분리하는 기술입니다. 세포 소기관, 단백질, DNA 등 다양한 생체 물질을 분리하는 데 사용됩니다.
7. 크로마토그래피 (Chromatography):

- 혼합물을 이동상과 고정상의 상호작용을 이용하여 분리하는 기술입니다. 다양한 종류의 크로마토그래피가 있으며, 물질의 특성에 따라 적절한 방법을 선택하여 사용합니다.
오늘은 생명과 대표적인 실험에 대해서 이야기해보았습니다.
자세하게 이야기하진 못 했지만, 이정도만 하더라도 기본적인 실험은 대부분 포함하고 있어요.
실험을 하는 연구실이라면 어딜 가더라도 이 정도는 한다...! 정도의 대표적인 실험을 가져왔습니다.
모쪼록 도움이 됐으면 좋겠네요!
'대학원과 진로 이야기' 카테고리의 다른 글
| 내가 박사 과정을 가지 않은 이유는... (0) | 2025.03.30 |
|---|---|
| 생명과 대학원은 누가 가는 걸까? (0) | 2025.03.29 |